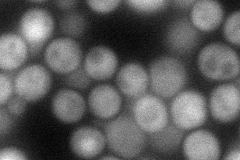
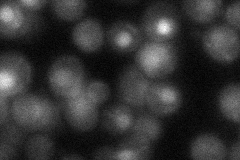

View description
Putative protein predicted to have carbon-sulfur lyase activity; green fluorescent protein (GFP)-fusion protein localizes to the nucleus and the cytoplasm; YNML082W is not an essential gene
Localization:
Intensity:
Fold change:
Significance:
-
C’ GFP library in SD

cytosol34.59 -
N' NOP1pr-GFP in SD

cytosol,nucleus66.1489 -
N' TEF2pr-mCherry in SD
cytosol78.5273 -
N' NATIVEpr-GFP in SD
nucleus32.1912 -
N' TEF2pr-VC and Cyto-VN in SD

cytosol45.8793 -
C’ GFP library in SD+DTT

cytosol36.721.06No -
C’ GFP library in SD+H2O2

nucleusN/AN/ANo -
C’ GFP library in Starvation Media

nucleusN/AN/AYes -
C’ GFP library on the background of Pup2-DaMP

cytosol -
C’ GFP library on the background of CCT mutant

cytosol39.97061.15534No
